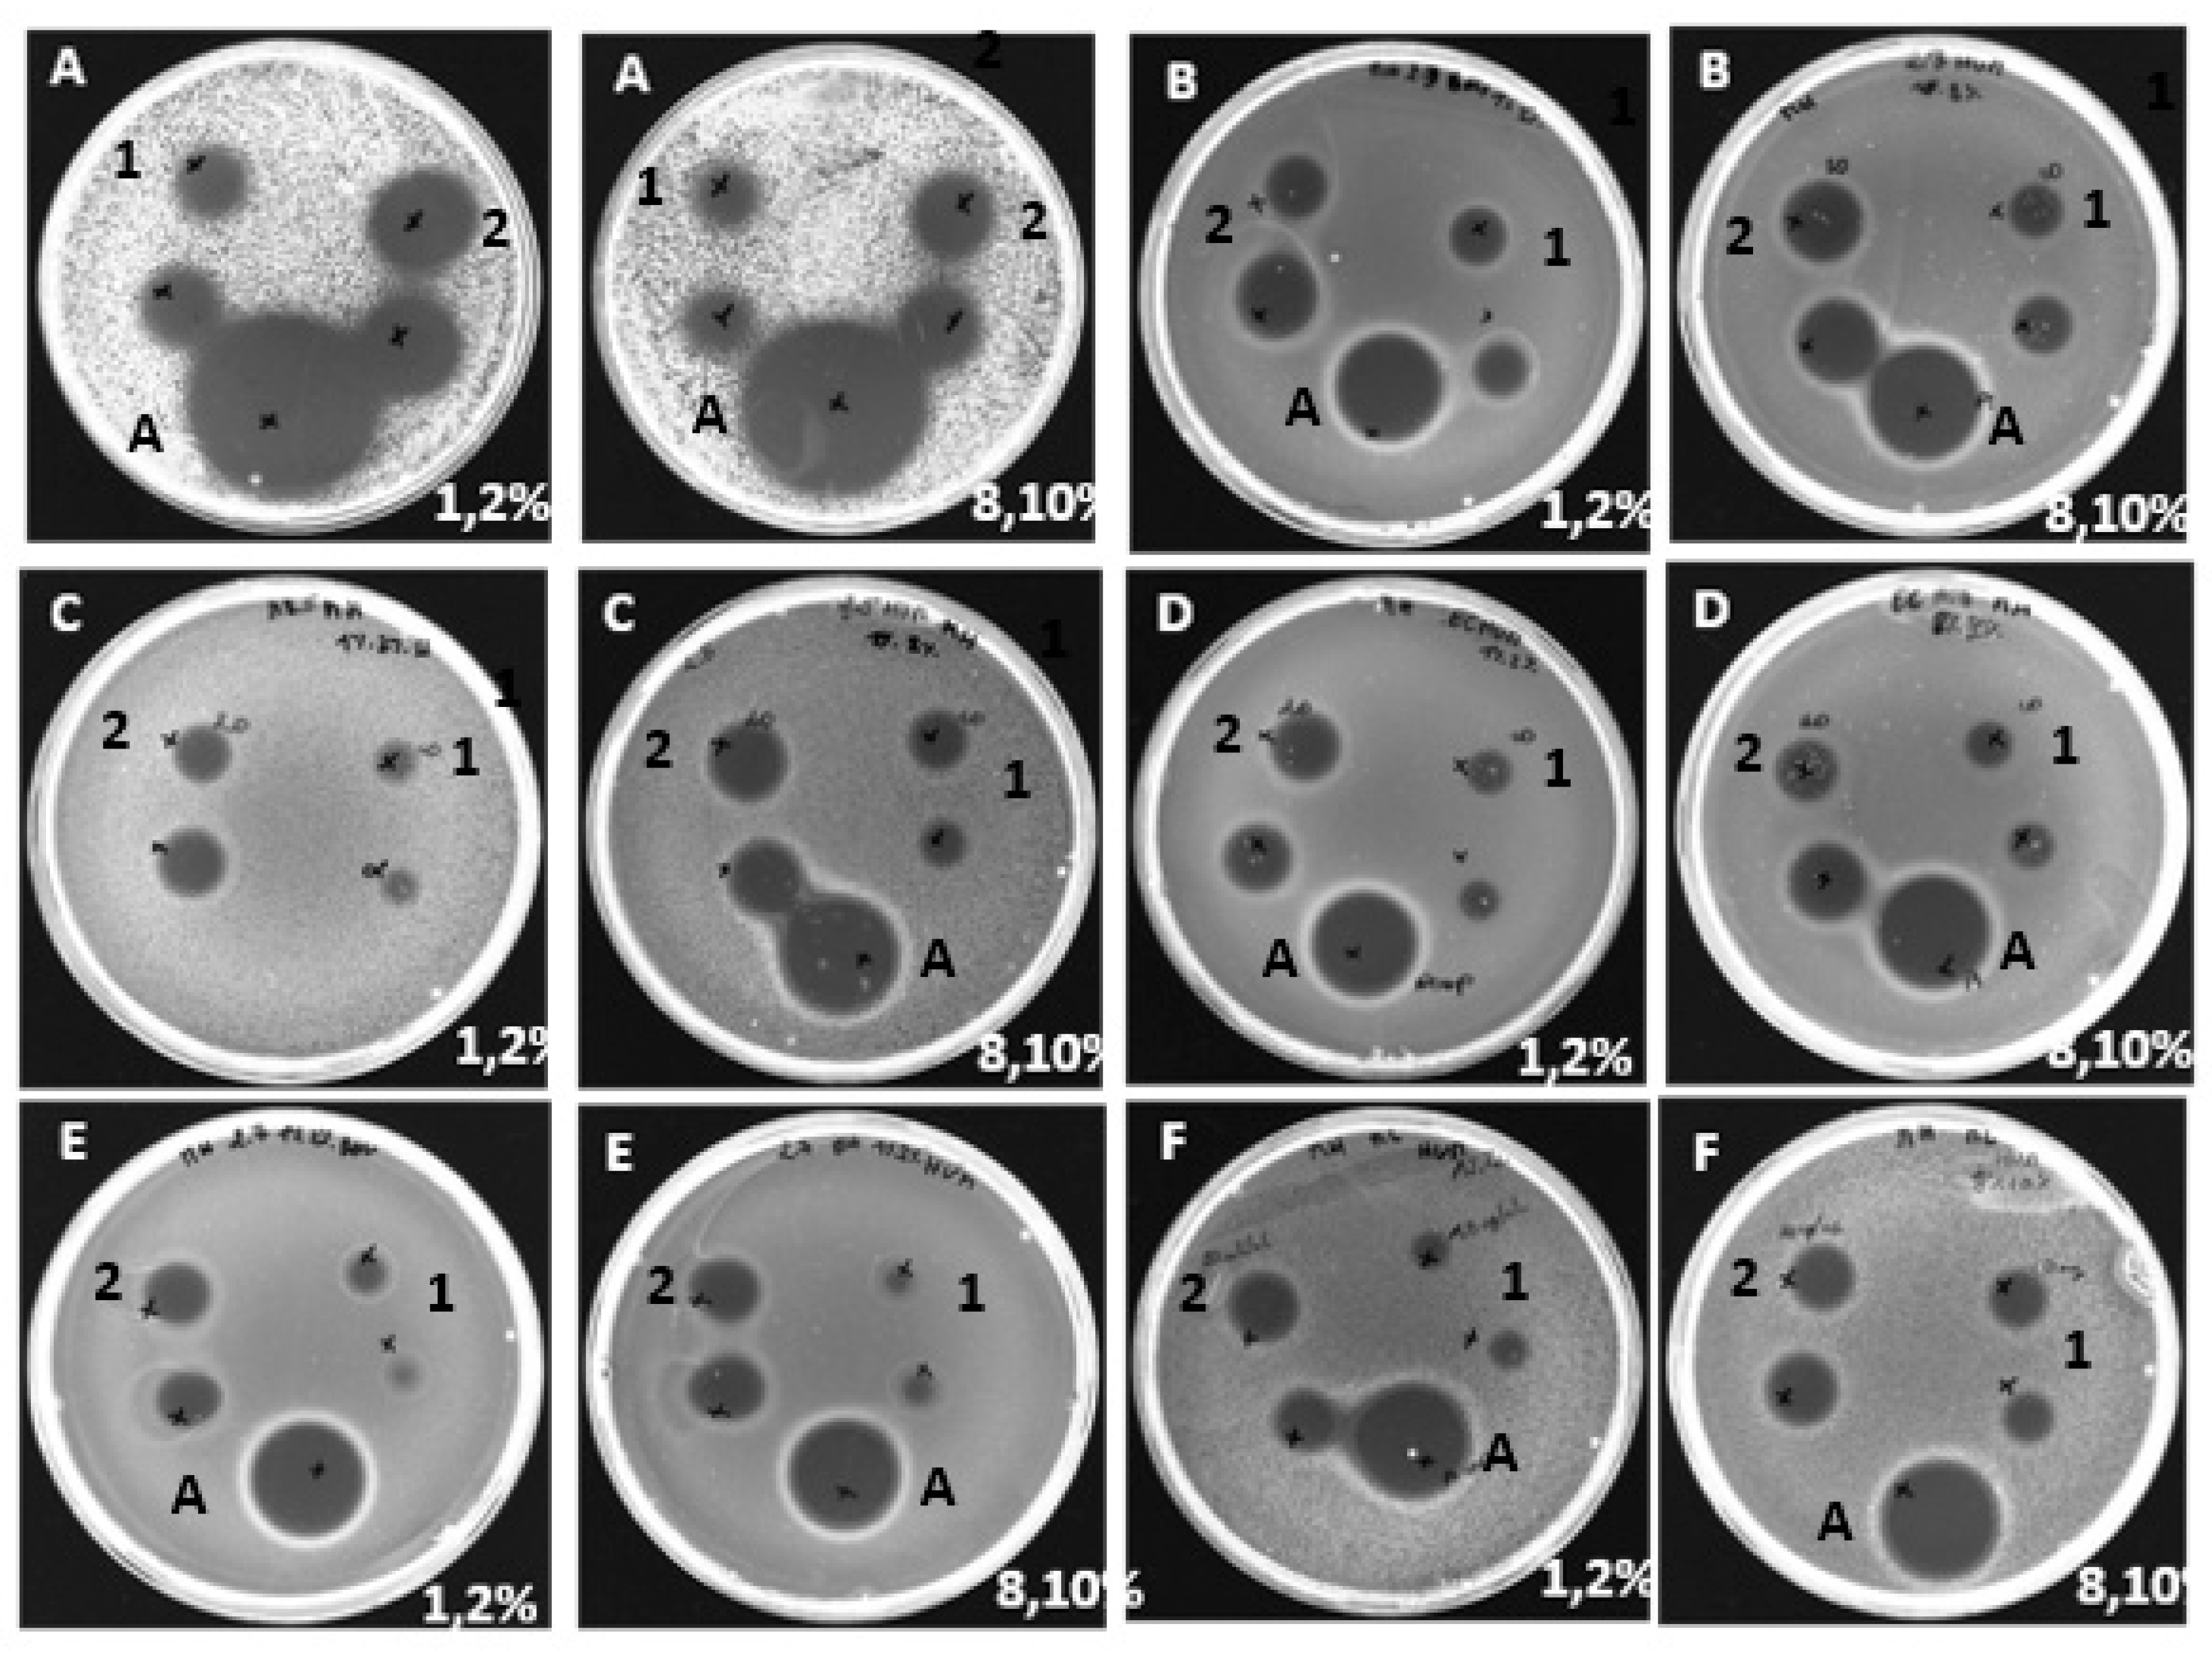
Preprints 78648 g001

1. Introduction
For many years, agrifood proteins have been considered an important source of biologically active peptides. Indeed, they have been widely used in the food and pharmaceutical industries as components of functional foods for humans and animals. In addition, these peptides have been exploited in the process of discovery and development of potential naturally occurring drug candidates, replacing synthetic compounds (Bah et al., 2013, Castro et Sato, 2015, Przybylski et al.; 2016).
Among these proteins, hemoglobin is of particular interest because it constitutes more than half of the proteins listed in the databases listing the various activities of active peptides [
1,
2] this latter consists of a tetramer comprising two α- and two β-globin chains, each containing a proto-heme group [
3].
The first hemoglobin-derived peptide with a biological use was discovered in 1971 by Schally et al. [
4]. It is a decapeptide that has been identified to be a 1–10 fragment of β-chain of hemoglobin and has growth hormone-releasing action from the porcine hypothalamus. Since this discovery, other hemoglobin-derived peptides with different biological functions have been identified, such as the analgesic peptides kyotorphin [
5] and neokyotorphin [
6,
7], corresponding to C-terminal sequences 140-141 and 137-141 of α-globin, which were discovered in 1979 and 1982 from bovine brain. Proteolytic treatment of hemoglobin also produces a series of peptides with opioid-like activity, called hemorphins, which were detected by Brantl et al [
8]. Since then, systematic studies of the peptide composition of various tissue extracts have led to the discovery of a large number of new peptides, the structure of which is mainly derived from α- and β-globin chains [
9].
In particular, the hydrolysis of bovine hemoglobin by pepsin generates many peptides with different biological activities, including opioid [
10,
11], hematopoietic (Vercaigne-Marko et al. 2000) and antihypertensive [
13]. However, antimicrobial activity is the most commonly reported in studies [
14,
15,
16,
17]. The peptide α137-141 (neokyotorphin, 653 Da, pI of 10.5), an antimicrobial peptide found in bovine hemoglobin, has recently been identified as an effective natural preservative to protect meat during storage and distribution [
17]. However, human hemoglobin, like bovine hemoglobin, contains a large number of proteins that could be used to generate bioactive peptides. Some studies have thus shown that human hemoglobin is an ideal substrate for proteolysis and generation of bioactive peptides with human or animal health benefits. Furthermore, by mapping specific regions of the hemoglobin molecule using synthetic peptides, Parish et al. [
18] demonstrated the antimicrobial activity of intact human hemoglobin tetramers, separated alpha and beta subunits, and identified the 30 carboxy-terminal amino acids of the beta subunit as being responsible for significant antimicrobial activity [
19].
The main objective of this study was to produce bioactive peptides through the enzymatic hydrolysis of human and bovine hemoglobin (used as a control group, laboratory model) and to demonstrate their bioactive properties. The focus was on the production of a specific peptide, α137-141, which is often obtained through this method [
13,
15,
20]. The secondary objectives were to evaluate the biological activity of the peptides. To achieve this, the study measured the antibacterial activity of the hydrolysates using the agar diffusion method and determining the minimum inhibitory concentration against six different bacteria. In addition, the antioxidant activity was evaluated using several methods such as the inhibition activity of β-carotene bleaching, DPPH radical scavenging activity assay, total antioxidant capacity, and ABTS●+ radical scavenging assay. Finally, the study identified the bioactive peptides generated by UPLC-MS/MS.
2. Results and Discussion
2.1. Biological Activities of the human and bovine Hydrolysates
2.1.1. Antibacterial Activity
2.1.1.1. Antimicrobial test on Petri dish
According to
the Table 1 presented, all human and bovine hemoglobin hydrolysates showed antibacterial activity against the six bacterial species tested, with a clear zone of bacterial growth inhibition observed at a concentration of 20 mg/mL. The results showed that concentration was a key factor, irrespective of the amount of hemoglobin substrate used (1%, 2%, 8% or 10% w/v). Overall, there was no significant difference in antibacterial activity between human and bovine hemoglobin hydrolysates against any given species, with the exception the
Salmonella Newport strain at all concentrations. In addition, the α137-141 peptide also showed antibacterial activity against all tested strains, confirming the results previously reported by Catiau et al. [
21]. The results obtained for bovine and human hemoglobin hydrolysates agree with the results of previous research conducted by Nedjar-Arroume et al. [
15,
17,
22,
23].
Table 1.
Antibacterial activity of human and bovine hemoglobin hydrolysates obtained with treatment by pepsin and α137-141 standard.
Table 1.
Antibacterial activity of human and bovine hemoglobin hydrolysates obtained with treatment by pepsin and α137-141 standard.
| |
Hemoglobin Hydrolysates |
| |
1 % |
2 % |
8 % |
10 % |
α 137-141 |
| Bacteria strains |
Bovine |
Human |
Bovine |
Human |
Bovine |
Human |
Bovine |
Human |
Bovine |
Human |
| Kocuriarhizophila |
+++ |
+++ |
+++ |
+++ |
+++ |
+++ |
+++ |
+++ |
+++ |
- |
| Staphylococcus aureus |
+++ |
+++ |
+++ |
+++ |
+++ |
++ |
+++ |
++ |
+++ |
- |
| Listeria monocytogenes |
++ |
++ |
++ |
++ |
++ |
++ |
++ |
++ |
++ |
- |
| Escherichia coli |
++ |
+ |
+ |
+ |
+ |
+ |
++ |
++ |
+ |
- |
| Salmonelle Newport |
++ |
+ |
++ |
+ |
++ |
+ |
++ |
+ |
+ |
- |
| Micrococcus luteus |
++ |
++ |
++ |
++ |
++ |
++ |
++ |
+ |
++ |
- |
3.1.1.2. MIC Determination of Antibacterial Peptide Hydrolysates
Figure 1.
Antibacterial activity of human hemoglobin hydrolysates (1, 2, 8 et 10% (p/v)) obtained with treatment by pepsin. A method based on the diffusion of the antibacterial agent in an agar medium inoculated with a target strain: Kocuriarhizophila (A), Staphylococcus aureus (B), Listeria monocytogenes (C), Escherichia coli (D), Salmonella Newport (E), Micrococcus luteus (F), and 1-2 refer to (10 and 20 mg/mL human HB hydrolysate), respectively, control +: ampicilin (A).
Figure 1.
Antibacterial activity of human hemoglobin hydrolysates (1, 2, 8 et 10% (p/v)) obtained with treatment by pepsin. A method based on the diffusion of the antibacterial agent in an agar medium inoculated with a target strain: Kocuriarhizophila (A), Staphylococcus aureus (B), Listeria monocytogenes (C), Escherichia coli (D), Salmonella Newport (E), Micrococcus luteus (F), and 1-2 refer to (10 and 20 mg/mL human HB hydrolysate), respectively, control +: ampicilin (A).
According to the experimental design, the samples were evaluated for their antimicrobial activity as a function of the initial hemoglobin concentration, namely 1%, 2%, 8% and 10% (w/v) for human and bovine hydrolysates with a degree of hydrolysis DH=10%. The MIC values of the hydrolysates were measured, and the results showed that each sample exhibited activity against both Gram-positive and Gram-negative bacteria. Peptides active against K. rhizophila, S. aureus and L. monocytogenes showed significantly lower MIC values (between 0.15 and 0.62 mg/mL) than those found for M. luteus, E. coli and S. Newport (between 5 and 10 mg/mL).
The antibacterial activity of human and bovine hydrolysates against K. rhizophila revealed MIC values of 0.15 mg/mL for all concentrations tested (1%, 2%, 8% and 10% w/v). Similarly, all hydrolysates, whether bovine or human, showed strong antibacterial activity against S. aureus and L. monocytogenes, with MIC values of 0.31 mg/mL and 0.62 mg/mL respectively for all concentrations tested. These results suggest that bovine and human hydrolysates exhibit equivalent and potent antibacterial activity. Furthermore, similar antibacterial activity was observed against E. coli, with MIC values of 10 mg/mL, as well as against Micrococcus luteus, with MIC values of 5 mg/mL, for all samples.
Finally, the results showed that the antibacterial activity of bovine hemoglobin hydrolysates against
Salmonella Newport was significantly higher than that of human hydrolysates. In fact, for all the concentrations tested, the MIC of bovine hydrolysates was 5 mg/mL, i.e. half the MIC of 10 mg/mL observed for human hydrolysates. These results confirm those obtained previously using the agar diffusion method. It is important to note that these strains are commonly implicated in the biological alteration of foodstuffs, both in production and distribution [
24]. The results obtained have been summarized in the following
Table 2.
2.1.2. Antioxidant Activities of human and Bovine Hemoglobin Hydrolysates
2.1.2.1. β-. carotene bleaching inhibition activity.
In this study, the lipid peroxidation inhibition activity of human and bovine hemoglobin hydrolysis (as a control) was measured by evaluating their ability to prevent linoleic acid oxidation in an emulsified model system. Namely, products of lipid oxidation can cause protein oxidation, while carbohydrates are less sensitive to oxidation [
25].
The antioxidant activity of human and bovine hemoglobin hydrolysates (as a control) was measured using the β-carotene bleaching assay, shown in
Figure 2.
The effects of various doses of hydrolysates were evaluated and contrasted with those of a synthetic bioactive peptide produced from hemoglobin hydrolysis, neokyotorphin (NKT, 0.5 mg/mL), as well as a standard antioxidant, BHT (0.5 mg/mL). Depending on their concentration, all hydrolysates inhibited β-carotene oxidation to varying degrees. Antioxidant activity nearing 100% signifies comparable efficacy to the reference antioxidant BHT (100 ± 1.12%).
The results showed that all hydrolysates inhibited β-carotene oxidation to different degrees depending on the concentration, with a relative antioxidant activity (RAA) of NKT that is 84.95 ± 5.63%, statistically lower (p< 0.05) but close to that of BHT. Thus, this peptide has a lipid protection capacity close to that of BHT.
Furthermore, there was not a significant difference (p > 0.05) in the antioxidant activity of human and bovine hemoglobin hydrolysates at any dosage of 1 mg/mL, 5 mg/mL, or 10 mg/mL, independent of the initial substrate percentage (at 1, 2, or 10%). In addition, the relative antioxidant activity (%) increased with increasing protein hydrolysate concentration. Among the tested concentrations, it was observed that a concentration of 10 mg/mL displayed significantly higher antioxidant activity compared to other concentrations. For human samples, the respective antioxidant activities were recorded as 99.26 ± 0.81%, 98.14 ± 6.35%, 98.9 ± 1.23%, and 98.7 ± 9.17% for concentrations of 1%, 2%, 8%, and 10% (p<0.05). Similarly, for bovine samples, the corresponding antioxidant activities were 99.3 ± 3.6%, 100.6 ± 1.1%, 98.8 ± 2.6%, and 99.8 ± 1.5% for concentrations of 1%, 2%, 8%, and 10% (p<0.05). Notably, at a concentration of 10 mg/mL, the observed antiradical activity closely resembled that of BHT at 0.5 mg/mL. These findings suggest that these products have the ability to protect lipids and can be considered as primary antioxidant scavengers of free radicals in emulsion.The antioxidant activity does not significantly difference between bovine and human hemoglobin hydrolysates as shown in the dose-effect curves A & C.
It's interesting to note that, when compared to BHT at 0.5 mg/mL, the relative antioxidant activity of phenolic compounds extracted from olive oil in the traditional manner is 67.40 ± 1.02%, which can be used to compare the study's findings with those of other substances [
26]. The antioxidant activity of our hydrolysates, which were dissolved at a concentration of 5 mg/mL, is approximately corresponding to this.
2.1.2.2. DPPH free radical scavenging capacity
The method of DPPH radical scavenging activity is based on the ability of our hydrolysates to capture the DPPH● radical. It is a spectrophotometric method at 517 nm following the absorption decrease, recently described by Molyneux [
27].
The results presented in
Figure 3 clearly demonstrate that both human and bovine hydrolysates have a high DPPH free radical scavenging activity. Ansignificativeincrease in their antioxidant activity is observed as the peptide concentration increases (1, 2, 8, and 10 mg/mL). The results obtained are in agreement with the conclusions reported in the previous work carried out by [
23], who observed that DPPH scavenging activity increased with increasing concentrations of 1% (w/v) bovine hemoglobin hydrolysates (2.5-10 mg/mL) using pepsin as well.
The results presented in the following figures showed no significant difference (p > 0.001) between bovine and human hydrolysis samples for the concentrations of 1, 5, and 10 mg/mL regardless of the increase in the initial concentration of bovine and human hemoglobin substrate (1 to 10% (w/v)).When the substrate concentration was set at 10 mg/mL, it was found to have significantly higher antioxidant activity (p < 0.05) than the other concentrations. The results obtained were 75.8±0.70; 74.9±1.44. 75.9±0.64; 77.9±4.70) 1. 2. 8 and 10% respectively for human samples and (76.9 ±1.67; 73.9±2.33; 74.3±2.08; 75.5±0.70) respectively for bovine samples.
Second, the results of the DPPH free radical scavenging activity of the peptide hydrolysates were calculated in terms of the Trolox equivalent antioxidant capacity (TEAC) and half-maximum inhibitory concentrations (IC
50). The IC
50 value, which represents the concentration of a sample needed to achieve 50% free radical inhibition, is typically used to assess free radical scavenging activity. The capacity to scavenge free radicals increases as the IC
50 value decreases. The tested hemoglobin hydrolysates' IC50 and TEAC values were compared, and the results are shown in
Table 3.
The results showed that hydrolysates from human and bovine hemoglobin had similar effects on the ability to trap the DPPH radical (p >0.05), with IC50s for 1, 2,8 and 10%, respectively, as follows: 1%: 3.07 ± 0.34mg/mL; 2%: 2.63 ± 0.31mg/mL; 8%: 2.45 ± 0.28mg/mL; 10%: 2.68 ± 0.32mg/mL for the human samples and 3.83 ± 0.40; 3.26 ± 0.36; 3.01 ± 0.32; 3.22 ± 0.38 mg/mL, for those from bovine. However, NKT and Trolox showed even higher activity, with IC50s of about 0, 83 ±0,09 mg/mL and 0, 38 ±0, 03mg/mL, respectively, but both statistically lower than the hydrolysates of the two species.
Regarding TEAC, the same conclusion can be drawn, the values in humans did not differ significantly (p <0.05) compared to bovine regardless of the increase in substrate concentration, from 1 to 10% (w/v). When the results were Compared with Trolox, it was observed that the DPPH radical scavenging activity in bovine and human was lower, with a TEAC value less than 1. In addition, the activity of NKT was found to be higher, more than twice that of peptide hydrolysates with a value of 0,45± 0,07.
2.1.2.3. Antioxidant properties products by ABTS assay
The ABTS radical scavenging method is based on the ability of the molecules to inhibit cation radicals. This consists of a measurement of antioxidant activity by spectrophotometric tracking of the discoloration of the reaction mixture, described by Re et al. [
28]. Trolox is used as a reference for comparisons. The results presented in
Figure 4 show that both human and bovine hydrolysates have a strong ABTS radical inhibition capacity. As the peptide concentration increases (1, 5 and 10 mg/mL), a significant increase in antioxidant activity is observed. This assay also confirms the results obtained in previous work conducted by [
23]. The following figures show no significant difference (p>0.05) between bovine and human hydrolysis samples for the concentrations of 1,5 and 10 mg/mL, regardless of the increase in the initial concentration of bovine and human hemoglobin substrate (1-10% (w/v)). The antioxidant activity of the substrate was found to be considerably higher (p>0.05) at 10 mg/mL compared to the other doses. The results of the IC
50 and TEAC comparative tests of the hydrolysates are presented in
Table 4
It was necessary to use concentrations of human hemoglobin hydrolysates of 3.24 ± 0.38 to 3.56 ± 0.45 mg/mL to inhibit 50% of ABTS radicals, whereas for bovine hemoglobin hydrolysates it was between 3.74 ± 0.53 to4.38 ± 0.56 mg/mL. The results of the statistical analysis revealed a no significant difference (p < 0.05) in CI 50 values between the two types of hydrolysates, although the values were very close. Regarding NKT, a concentration of 0,64 ±0,06 mg/mL was required to inhibit 50% of ABTS radicals, which is close to the value of Trolox, but statistically different (p < 0.05). Both bovine and human hemoglobin hydrolysates exhibited lower radical scavenging activity compared to Trolox, as indicated by their TEAC values being less than 1. However, the reference bioactive peptide, NKT, demonstrated a very similar radical scavenging activity to Trolox, with a value of 0.90 ± 0.05.
These results indicate that bovine and human hemoglobin hydrolysates (from 1 to 10%) have antioxidant properties but their efficiency is lower than that of Trolox because of the competitiveness between the many bioactive peptides they contain.
2.1.2.4. Evaluation of total antioxidant capacity
To evaluate the total antioxidant capacity of the hydrolysates, the TEAC unit (mg/mL) was used at three different concentrations (1, 5and 10 mg/mL), using Trolox as the reference antioxidant. The results obtained from
Figure 5 show a direct relationship between the hydrolysate concentration and the increase in antioxidant capacity. Consistent with expectations, it was found that the concentration of 10 mg/mL displayed significantly superior antioxidant activity compared to the other concentrations that were tested. This observation held true for both human and bovine samples.
Furthermore, it was observed that bovine hydrolysates showed the highest TEAC compared to human hydrolysates for most of the concentrations tested (1, 5, and 10 mg/mL) and regardless of the initial substrate concentration, from 1 to 10% (w/v). For BHT (0.5 mg/mL), an antioxidant activity of 2.02 ± 0.007 mg/mL was found under the same conditions. The TEAC of all hydrolysates, whether of human or bovine origin, at 10 mg/mL is approximately two times lower than that of BHT at 0.5 mg/mL. Therefore, the antioxidant activity of the 10 mg/mL hydrolysate is equivalent to 0.25 mg/mL BHT by the phosphorus-molybdenum method.
Both human and bovine hemoglobin hydrolysates exhibited significant antioxidant properties, indicating their potential as antioxidants regardless of the initial substrate concentration, from 1 to 10% (w/v). Therefore, hydrolysis is an important step to generate smaller bioactive peptides that possess biological activity, such as significant antiradical activities. It is important to note that the antioxidant properties of peptides are influenced by various factors such as their molecular size, composition, hydrophobicity, and the electron transfer capacity of the amino acid residues in the sequence [
29].These results suggest that hemoglobin hydrolysates can be used as antioxidant agents to combat free radicals that cause cellular damage and disease.
2.2. Study of the antimicrobial, antioxidant activity and peptidomic analysis of fractions of peptide hydrolysates
The results of the study on the antimicrobial and antioxidant activity and the peptidomic analysis of the peptide fractions obtained after 3 hours of hydrolysis of human and bovine haemoglobin with a degree of hydrolysis DH=10% are presented in the different figures. In figure 6 A, the chromatographic hydrolysis profiles of bovine and human hemoglobin are shown. Fraction one (1) corresponds to the NKT peptide of interest, and subsequent fractions were collected every 5 minutes. The aim was to identify the most active fractions with a view to adding value to these high added value compound. The
Figure 6B shows the results of the antimicrobial activity of the peptide fractions against six bacterial strains. The results show that fraction 1 exhibits strong antibacterial activity with a MIC of 1 µg/mL against
Kocuria rhizophila and
Listeria monocytogenes, as well as a MIC of 2 µg/mL against
Staphylococcus aureus, 4 µg/mL against
Salmonella Newport, and finally 8 µg/mL against
Escherichia coli and
Micrococcus luteus. In both human and bovine hemoglobin, fraction 1 (representing NKT) has one of the highest levels of antimicrobial activity. The last fraction, 9, corresponds to heme, which has not been hydrolysed and remains unchanged. Numerous studies have reported good bacterial activity of heme (Ivanov et al., 1997). However, it is interesting to note that all fractions showed antibacterial activity, although the strength of the activity varied between strains. Fractions 3, 4, 5 and 6 showed more interesting MICs than fractions 2, 7 or 8.
Antioxidant activity was assessed using the ABTS
●+ radical scavenging method and is presented in
Figure 6B. Fraction 2, containing NKT, again shows very promising antioxidant activity with over 75% inhibition of ABTS
●+. These results are consistent with previous studies by Abou-Diab et al.(2020b) and Przybylski et al. 2016. Fractions 4, 5, 6 and 7 demonstrate higher antioxidant activity in human and bovine hemoglobin, with more than 50% inhibition of ABTS
●+. In contrast, the other fractions show moderate activity, but with more than 25% inhibition of ABTS
●+.
Table 4.
Antimicrobial activity and peptidomic of human and bovine hemoglobin hydrolysate fraction.
Table 4.
Antimicrobial activity and peptidomic of human and bovine hemoglobin hydrolysate fraction.
| |
Hemoglobin fractions (µg/mL) |
| Bacteria strains |
1 |
2 |
3 |
4 |
5 |
6 |
7 |
8 |
9 |
| B |
H |
B |
H |
B |
H |
B |
H |
B |
H |
B |
H |
B |
H |
B |
H |
B |
H |
| Kocuria rhizophila |
1 |
1 |
2 |
2 |
4 |
4 |
2 |
4 |
2 |
1 |
2 |
4 |
4 |
4 |
8 |
4 |
2 |
2 |
| Staphylococcus aureus |
2 |
2 |
4 |
4 |
4 |
8 |
2 |
4 |
2 |
2 |
2 |
4 |
8 |
- |
- |
- |
8 |
4 |
| Listeria monocytogenes |
1 |
1 |
625 |
625 |
8 |
8 |
4 |
4 |
4 |
4 |
2 |
4 |
8 |
8 |
- |
- |
4 |
4 |
| Escherichia coli |
8 |
8 |
4 |
8 |
4 |
4 |
4 |
4 |
15.6 |
8 |
4 |
4 |
8 |
15.6 |
8 |
4 |
310 |
310 |
| Salmonelle Newport |
4 |
4 |
625 |
625 |
2 |
4 |
4 |
4 |
4 |
4 |
8 |
15.6 |
310 |
310 |
8 |
- |
4 |
4 |
| Micrococcus luteus |
8 |
8 |
2 |
4 |
- |
8 |
2 |
4 |
4 |
4 |
8 |
4 |
- |
- |
8 |
8 |
625 |
625 |
In studies by Abou-Diab et al. (2020b) and Przybylski et al. (2016), the 'Zipper' mechanism produced a wide variety of peptides from bovine hemoglobin hydrolysate. Nevertheless, a comparative analysis of the peptide populations in the fractions was performed by UPLC-MS/MS. In order to present the results clearly, a histogram (
Figure 6C) showing the number of unique peptide sequences identified was used. This allows a clear and precise visualisation of the differences and similarities between the peptide populations in the fractions. Furthermore, by cross-referencing the results, it was observed that the same fractions exhibited both antioxidant and antibacterial properties in both species, notably fractions 4, 5, 6 and 7. This observation can be explained by the greater number of peptide sequences identified in these fractions.
2.3. Identification of antimicrobials peptides resulting from human and Bovine Hemoglobin Hydrolysis
The results obtained by UPLC-MS/MS revealed that some of the identified peptides exhibit antimicrobial and antioxidant properties, as reported in previous studies [
15,
23,
30,
31,
32], and are listed in the table below. The results of this comparative analysis revealed similarities and differences in their composition. Most of the peptides identified in cattle were found in humans without modification, but some antimicrobial peptides present in bovine hemoglobin were not found in their original form in human hemoglobin. This difference could be due to differences in the cleavage sites or modifications of the peptide sequence. For example, the antimicrobial peptide KLLSHSL located at α99-105 became KLLSHCL in human hemoglobin or the small peptide LAHRYH located at β140-145 became LAHKYH. However, there is only one amino acid that differs between the peptides. This shows that this amino acid change does not lead to a total loss of antimicrobial activity [
33]. It is also interesting to note that the peptides identified are present in the same bovine and human protein fractions, suggesting that their release occurred simultaneously during the hydrolysis process.
Table 6.
Antimicrobial peptide sequences identified by UPLC-MS/MS from bovine and human hemoglobin hydrolysis fractions.
Table 6.
Antimicrobial peptide sequences identified by UPLC-MS/MS from bovine and human hemoglobin hydrolysis fractions.
| Fraction (min) |
Position |
Sequence |
MolecularWeight (Da) |
Bovine |
Human |
| Antimicrobiots |
1(6-8) |
α137-141 |
TSKYR |
653 |
+ |
+ |
| 2(8-10) |
α99-105 |
KLLSHSL |
796 |
+ |
KLLSHCL |
| α100-105 |
LLSHSL |
668 |
+ |
- |
| β140-145 |
LAHRYH |
795 |
+ |
LAHKYH |
| 3(10-15) |
α99-106 |
KLLSHSLL |
910 |
+ |
KLLSHCLL |
| 4(15-20) |
α133-141 |
STVLTSKYR |
1054 |
+ |
+ |
| 6(25-30) |
α37-46 |
PTTKTYFPHF |
1238 |
+ |
+ |
| α36-45 |
FPTTKTYFPH |
1238 |
+ |
+ |
| α32-41 |
FLSFPTTKTY |
1204 |
- |
+ |
| 7(30-35) |
α34-46 |
LSFPTTKTYFPHF |
1585 |
+ |
- |
| α33-46 |
FLSFPTTKTYFPHF |
1732 |
+ |
- |
| Antioxydant |
α137-141 |
TSKYR |
653 |
+ |
+ |
However, it is difficult to determine which fraction is more active in terms of bioactive peptides, for two main reasons. On the one hand, although there are more than 200 peptides identified for each species at this stage of hydrolysis, only a few of them have been reported in the literature to have antibacterial properties. On the other hand, the degree of hydrolysis (DH) has an influence on the composition of the resulting peptide populations, as the molecular weight of the peptides decreases as DH increases (Przybylski et al., 2016). However, in this study, hydrolysis was only performed at a DH of 10 and was not performed at other DHs. Nevertheless, these results revealed the presence of several new bioactive peptides in human hemoglobin, some of which were already known but others were discovered for the first time, such as antibacterial peptides (α37-46 PTTKTYFPHF; α36-45 FPTTKTYFPH; α137-141 TSKYR; α133-141 STVLTSKYR) and an antioxidant (α137-141 TSKYR). The peptide a137-141 is of particular interest in this study, as it has been identified as a natural preservative to protect meat during storage or distribution. Przybylski et al. (2016) showed that neokyotorphin, present in bovine and porcine cruor hydrolysates, could reduce lipid oxidation by up to 60% and inhibit microbial growth for 14 days, with similar effects to the commonly used preservative, butylated hydroxytoluene (BHT). In this study, the peptide a137-141 was identified for the first time in human hemoglobin hydrolysate.
The results obtained emphasize the potential of human hemoglobin as a rich source of antimicrobial and antioxidant peptides, making it highly valuable for applications in the food and pharmaceutical industries.
3. Materials and methods
3.1. Materials: chemicals and cultures used
The chemicals used for the dosages are: 1,1-diphenyl-2-picrylhydrazyl (DPPH), butylated hydroxytoluene (BHT), 2,2′-azino-bis 3-ethylbenzothiazoline-6-sulfonic acid (ABTS), 6-hydroxy-2 ,5,7,8-tetramethylchroman-2-carboxylic acid (Trolox), β-carotene, and linoleic acid were procured from Sigma-Aldrich (Saint-Quentin Fallavier, France) A Milli-Q system was employed in the lab to produce ultra-pure water.
Purified bovine hemoglobin powder (H2625), dark brown and purified human hemoglobin (H7379), dark red, were obtained from Sigma-Aldrich. Hemoglobins were stored at 4°C before use. Standard neokyotorphin (α137-141) was purchased from GeneCust (Boynes, France) and stored at -20°C before use. Pepsin, a lyophilized powder from porcine gastric mucosa was purchased from Sigma-Aldrich (P6887, Saint-Quentin Fallavier, France). Pepsin activity was measured at 3250 AU/mg protein according to a protocol established by the supplier Sigma-Aldrich (Saint-Quentin-Fallavier, France). Storage at -20°C.
Bacterial species used: Listeria monocytogenes (ATCC 19112), Staphylococcus aureus (ATCC 13709), Micrococcus luteus (ATCC 9341), Escherichia coli (ATCC 8733), and Salmonella Newport (ATCC 6962) were from the American Type Culture Collection (ATCC, Rockville, MD, USA) Kocuriarhizophila (CIP 53.45), was from the Collection de l'Institut Pasteur (CIP, Paris, France).
3.2. Preparation of bovine hemoglobin hydrolysates
Conventional enzymatic hydrolysis using pepsin was used to compare two types of hemoglobin: bovine and human hemoglobin. Bovine hemoglobin is considered a "control" because it has been shown in several enzymatic hydrolysis studies to produce active peptides, including the peptide α137-141, which has various biological activities [
15,
17,
21,
34]. The results obtained were compared to this control.
3.2.1. Preparation of the stock solution
The stock solution was made by dissolving 15 g of purified human hemoglobin HH (or bovine hemoglobin BH) in 100 mL of ultrapure water. The solution was centrifuged at 6000 g for 30 minutes to recover the supernatant (Eppendorf AG, 22331 Hamburg, Centrifuge 5804 R, Brinkmann Instruments, Westbury, NY, USA). The effective concentration of HH (CHH) or BH (CBH) was calculated using the Drabkin method (Crosby, W.H. et al., 1954). A purified hemoglobin solution with precise concentrations of 1, 2, 8 and 10% (w/v) was prepared from the measured concentration.
2.2.2. Hydrolysis process
In order to denature the hemoglobin solution, which was initially in its native, so-called "globular" form, the pH was adjusted to 3.5 using 2 M hydrochloric acid which was added gradually. Pepsin (EC 3.4.23.1, 3200-4500 units’ mg -1 of protein), previously solubilized in ultrapure water, with an enzyme/substrate ratio of 1/11 (mole/mole), was added to begin the hydrolysis reaction. The samples were taken at T0, T 2.5, T 30, T 60, T 120, and T 180 min of hydrolysis, corresponding to different degrees of hydrolysis.
Then, the peptic hydrolysis reaction is stopped by adding 5 M NaCl sodium chloride to a final pH of 9, pH which deactivates the enzyme. Throughout the reaction the temperature was maintained at a constant 30 °C. The samples (triplicates) were stored at -20°C, then they were submitted to lyophilization, obtaining a powder which was then used for the test.
2.2.3. Fractionation of peptide hydrolysates by semi-preparative HPLC
In order to refine the research results, fractions were performed. To obtain more active peptides in one step, it was necessary to increase the concentration of the initial substrate used. For this purpose, a hydrolysate could be selected with a degree of hydrolysis of 10% and hydrolysis times of 3 hours. It was shown that increasing the concentration of peptides in the 10% (w/v) hydrolysate allowed the recovery of up to 10 times more active peptides, such as the α137-141 peptide, compared to the initial hydrolysate. This suggests an interesting valorization of the co-products, with a 10-fold enrichment (Przybylski, R et al.; 2016). Fractions were collected every 5 minutes using a liquid chromatography system. Chromatographic data were traced, acquired, and analysed using Waters software. Chromatographic procedures were performed with a semi-preparative C4 column (RP 2.6UM 150X2.1MM). The mobile phases were ultrapure water/trifluoroacetic acid (99:1, v/v) as solvent A, and acetonitrile/trifluoroacetic acid (99:1, v/v) as solvent B. Samples were filtered at 0.20 μm and then injected. On-line UV absorbance scans were performed between 200 and 390 nm at a rate of one spectrum per second, with a resolution of 1.2 nm [
16,
35]. The injection volume was 60 µL and the flow rate was 0.6 mL/min. A gradient was applied with solvent B increasing from 5% to 30% in 30 min, then to 60% for 10 min, and maintained until 47 min at 95%, then back to initial conditions. The tubes containing the different fractions were dried with speedVac and stored at -20°C.
2.2.4. Analysis RP-UPLC, mass spectrometry analysis
Aliquots of 10 µL of human and bovine hydrolysates, each with a concentration of 30 mg/mL, were centrifuged for 10 min. at 8,000 x g before being subjected to RP-HPLC-MS/MS analysis in triplicate. A C18 column (150 mm × 3.0 mm, 2.6 m, Uptisphere CS EVOLUTION, Interchim, France) was used to separate the peptides. Solvent A (0.1 v/v formic acid/99.9 v/v water) and Solvent B (0.1 v/v formic acid/99.9 v/v acetonitrile (ACN)) made up the mobile phases. The ACN gradient (flow rate 0.5 mL.min-1) was as follows: from 5% to 30% solvent Bover 40, from 30% to 100% solvent B over 10 min, followed by washing and equilibrating procedures using successively 100% and 1% solvent B for 5 min each.
The eluate was directed into the electrospray ionization source of the qTOFSynapt G2-Si™ (Waters Corporation, Manchester, UK) previously calibrated using a sodium format solution. Mass spectrometry (MS) measures were performed in sensitivity, positive ion, and data dependent analysis (DDA) modes using the proprietaryMassLynx software (Waters).
The capillary and cone voltages were set to 3000 and 60 V, respectively, while the source temperature was set at 150 °C. With a scan time of 0.2 s, MS data were gathered for m/z values between 50 and 2000 Da. For the MS/MS study, a maximum of 10 precursor ions with a 10,000-intensity threshold were used. When collecting MS/MS data, collision-induced dissociation (CID) fragmentation mode was used. A scan period of 0.1 seconds was specified, and the stated voltage ranges for the lower and higher molecular mass ions, respectively, were 8 to 9 V and 40 to 90 V. Every two minutes for 0.5 seconds, leucin + enkephalin ([M + H]+ of 556.632]) was injected into the system to monitor and rectify the measurement error throughout the duration of the analysis.
The chromatographed peptides were identified using protein database searches in the UniProt data bases that were limited to Bos taurus and Homo sapiens (access online on July 2022) using PEAKS® Studio XPro (v 10.6) (Bio informatics Solutions Inc., Waterloo, Canada). A mass tolerance of 35 ppm and an MS/MS tolerance of 0.2 Da were permitted. With pepsin designated as the hydrolysis enzyme, data searches were carried out. The relevance of protein and peptide identities was judged according to their identification score in the research software (using a p-value< 0.05 and a false discovery rate<1%).
2.3. Determination of the hydrolysates bioactivity
2.3.1. Antibacterial Activity
2.3.1.1. Antimicrobial test on Petri dish: Agar diffusion method
The determination of the antimicrobial activity of peptic hydrolysates of purified human and bovine hemoglobin was realized according to the method of Adje et al [
32]. This is a method based on the diffusion of the antibacterial agent within an agar medium seeded with a target strain. A total of six bacterial strains were tested for antibacterial activity:
Staphylococcus aureus (ATCC 13709),
Listeria monocytogenes (ATCC 19112),
Micrococcus luteus (ATCC 9341),
Kocuriarhizophila (CIP 53.45),
Escherichia coli (ATCC 8733) and
Salmonella Newport (ATCC 6962). It is important to note that these bacterial strains are commonly responsible for food spoilage [
21,
24]. These species being stored at -20 ° C in a nutritive broth containing glycerol. The pre-culture of the species was performed by inoculation: 50 µL of bacteria were added in 5 mL of Müller-Hinton medium (MH), the whole was incubated at 37°C under agitation (60 rpm) for 24h. Then, the absorbance of the cultures was determined with a spectrophotometer at 620 nm using the MH medium alone as a blank. In order to obtain an absorbance of 0.25 at 620 nm, a series of dilutions was performed in Tryptone Salt (TS), according to the type of bacteria, to obtain a final Colony Forming Unit CFU/mL. (CFU) to ×10
6: 1/1000 dilution for gram (-) bacteria and 1/100 dilution for gram (+) bacteria. The MH agar medium, previously casted and dried in Petri dishes, were inoculated by the inundation method: one milliliter of complete inocula from the last dilutions (1/100 or 1/1000) were put in contact with the agar for 20 minutes. Excess inoculum was removed by aspiration with a sterile pasteur pipette. These dishes were then dried under a laminar flow host for more than 30 minutes. Then, a spot deposit of 10 µL of 0.25 μm filtered samples, as well as the positive control were then deposited on the agar surface. After drying, the plates were incubated 24 hours at 37°C. The diameter of the clear zone of growth inhibition against a positive control, ampicillin (0.1 mg/mL) for all bacterial species and colistin (0.1 mg/mL) for
Escherichia coli, was used to quantify the antibacterial activity. This antimicrobial test was run three times.
2.3.1.2. Determination of the minimal inhibitory concentration (MIC)
The MIC ("Minimal Inhibitory Concentration") is the lowest concentration of the studied peptide hydrolysates that can inhibit the growth of the studied bacterial species.
This is a growth inhibition test in liquid medium carried out on a sterile 96-well microplate whose response is read after 24 hours of incubation [
36]. This test quantifies the antimicrobial activity of a hydrolysate, an isolated peptide, or any other antimicrobial agent. The Mueller-Hinton culture medium was chosen for this assay. Initially, 100 μL of this medium was added to each well and supplemented with 100 μL of peptide hydrolysates (40 mg/mL) leaving a negative control ranger. 100 μL bacterial suspension pre-diluted in Mueller-Hinton was added last to each well to a final bacterial load of 10 5CFU/mL. The negative control corresponds to the medium without bacteria, the positive control corresponds to 50 µL of culture medium contacted with 50 µL of bacterial suspension.
After incubation at 37°C for 24 hours, the inhibition of bacterial growth was assessed by measuring the absorbance at 600 nm using a microplate reader (Safas, model MP96 UV-Vis Spectrophotometer, Agilent Technologies, Santa Clara, CA, USA). The measurement of MIC values was performed in triplicate. The absorbance values obtained from wells containing peptide hydrolysates were compared to those of negative controls and a control culture. All data are presented as the mean ± standard deviation (SD) and represent the average of three replicates.
2.3.2. Antioxidant activity
In this study, four chemical in vitro assays based on several antioxidant mechanisms were used to determine the antioxidant activity of the peptides we generated as well as the peptide fractions and the synthetic peptide, neokyotorphin.
2.3.2.1. Antioxidant assay using the β-carotene bleaching method.
This method consists of spectrophotometrically monitoring the bleaching of β-carotene: loss of its yellow color, resulting from its reaction with radicals formed by the oxidation of linoleic acid in emulsion [
37]. The bleaching of β-carotene, measured by the decrease in initial absorbance at 470 nm, is slowed down in the presence of antioxidants, resulting in a lower oxidation kinetics [
38]. Koleva et al. (Koleva et al. 2002) indicated that the hydrolysate's capacity to prevent -carotene bleaching was assessed. A stock solution of -carotene (4 mg), linoleic acid (100 L), and Tween-40 (800 L) was dissolved in 4 mL of chloroform. After the latter had entirely evaporated at 45 °C under vacuum in a rotary evaporator (Heidolph, Schwabach, Germany), 400 mL of distilled water was added.
The capability of the hydrolysate to prevent the bleaching of -carotene was assessed, as Koleva et al. [
38] mentioned. A stock solution of β-carotene (4 mg), linoleic acid (100 L), and Tween-40 (800 L) was dissolved in 4 mL of chloroform. After the latter had entirely evaporated at 45 °C under vacuum in a rotary evaporator (Heidolph, Schwabach, Germany), 400 mL of distilled water was added. The mixture was then agitated vigorously. Before each experiment, the β-carotene/linoleic acid emulsion was freshly prepared.
In tubes with a sample (5 mL) of the emulsion were 500L of each sample that had been prepared using ultrapure water at various concentrations. Each sample's absorbance at 470 nm was assessed before and after being incubated for two hours at 50 °C (Shimadzu UV-1650 PC Spectrophotometer, Shimadzu Corporation, Kyoto, Japan). Butylated hydroxytoluene (BHT) was used as a positive control at a concentration of 0.5 mg/mL.
Equation (1) was used to calculate relative antioxidant activity:
where A blank consisted of 500 μL of distilled waterin place of the sample solution, A sample is the absorbance of samples (with the emulsion) and A control is the absorbance of BHT (with the emulsion). All the data are presented as mean ± SD and are the mean of three replicates.
2.3.2.2. DPPH radical scavenging capacity
According to the recently described method of Bersuder et al [
39], the DPPH (1,1-diphenyl-2-picrylhydrazyl) radical scavenging capacity of the samples was evaluated. An ethanolic stock solution of DPPH (0.02 mass %) as a source of free radicals was prepared 12-16 h before uses.
Each sample was diluted in ultrapure water to different concentrations and a volume of 500 μL was added to 250 μL of 99% ethanol and 375 μL of DPPH solution. The mixtures were vortexed before being incubated for 60 minutes at 30 °C in the dark. The absorbance of the mixture was measured at 517 nm against the blank consisting of pure ethanol. The scavenging capacity was measured spectrophotometrically (PC Shimadzu UV-1650 spectrophotometer, shimadzucorporation, Kyoto, Japan) by following the decrease in absorbance at 517 nm. The reaction mixture's lower absorbance indicates higher DPPH free radical scavenging activity. The same operational conditions were employed to compare BHT. The radical scavenging activity (RSA) is quantified as a percentage and calculated using the following formula (2).
where A blank is the absorbance of the control reaction (containing all reagents except the sample), A sample is the absorbance of samples (with the DPPH solution) and A control is the absorbance of BHT (with the DPPH solution).
The DPPH+ radical scavenging activity was expressed using the Trolox Equivalent Antioxidant Capacity (TEAC) values and half-maximal inhibitory concentrations (IC
50 ). The IC
50 was graphically estimated using linear regressions of the percentage curves of inhibition in response to various concentrations of the hydrolysates under test. It shows the sample volume needed for inhibiting 50% of DPPH radicals. value decreased as the compound's anti-free radical activity increased [
40].The concentration of standard Trolox, a water-soluble vitamin E analog, was utilized to calculate the TEAC value ([
41]. Standard Trolox had the same antioxidant capacity as a 1 mg/mL solution concentration of the antioxidant molecule under research.
In biology, it serves as a reference antioxidant for evaluating oxidative stress resistance. The results of each analysis, which were performed in triplicate, were provided as mean values with standard deviations.
2.3.2.3. Antioxidant properties products by ABTS assay
The method outlined by Re et al. [
28] was used to test the radical scavenging abilities of ABTS (2,2′-azino-bis 3-ethylbenzothiazoline-6-sulphonic acid). Aqueous interaction between 7 mM ABTS and 4.95 mM potassium persulfate formed the cationic radical ABTS
+. This was prepared 12 to 16 h before use. The solution was stable when kept at ambient temperature and protected from light. A portion of this solution was diluted with ethanol at 30 °C in order to attain an absorbance at 734 nm of less than one. The hydrolysates were first dissolved in various concentrations of ultrapure water, and then 10 μL of each sample was combined with 1 mL of the diluted ABTS
+ solution. Exactly 6 minutes after the initial mixing, the absorbance of ABTS
+ was determined at 734 nm and 30 °C using a Spectrophotometer (Shimadzu UV-1650 PC Spectrophotometer, Shimadzu Corporation, Kyoto, Japan). In each test, the proper solvent blanks were used. According to Equation (3), the result is expressed as the percentage inhibition:
The absorbance of samples (using the ABTS solution) is represented by A sample, while the absorbance of the control reaction (containing all reagents except the sample) is represented by A blank.
The ABTS+ radical scavenging activity was expressed using the half-maximal inhibition concentration (IC50) and TEAC values. The data presented includes the mean and standard deviation (SD) of three replicates.
2.3.2.4. Evaluation of total antioxidant capacity
The hydrolysates' total antioxidant capacity was assessed using the technique described by Prieto et al., [
42]. Based on an oxidation-reduction reaction, it is a simple and effective approach for evaluating antioxidant activity.
A phosphate/molybdenum (Mo3O16P4) green complex is formed at an acidic pH as a result of the reduction of molybdenum Mo, which is present as molybdate MoO4-2 ions, to molybdenum MoO2+in the presence of the hydrolysate. With the help of this assay, we were able to determine the peptides' antioxidant status by using the peptides in the hydrolysates as reducing agents in a colorimetric redox reaction. Prior to mixing with the reagent (0.6 M sulfuric acid, 28 mM sodium phosphate, and 4 mM ammonium molybdate), peptide hydrolysates were first dissolved in ultrapure water at different concentrations (2.5 mg/mL, 5 mg/mL, 10 mg/mL, and 20 mg/mL). An aliquot of 300 μL of each sample was then added. The tubes were covered, and they were incubated in a thermal block for 90 minutes at 95 °C.
After cooling at room temperature, each sample's aqueous solution's absorbance was measured at 695 nm against a control (Shimadzu UV-1650 PC Spectrophotometer, shimadzu corporation, Kyoto, Japan). A typical blank solution was made up of 3 mL of reagent solution and the necessary amount of the sample's solvent, and it was incubated in the same manner as the other samples. The positive standard used was BHT (0.5 mg/mL). For calibration, a Trolox solution with concentrations varying from 0 to 0.75 mg/mL was utilized. Equation (4) from the calibration line is used to represent antioxidant activity as Trolox Equivalent Antioxidant Capacity (TEAC) values (mg/mL):
The absorbance at 695 nm is denoted as A, and the equivalent antioxidant concentration is represented by C (mg/mL). The concentration is determined using the standard range curve equation of a reference antioxidant, such as Trolox. The values of a and b in the equation correspond to the origin and slope of the Trolox calibration line, respectively. All the data are expressed as the mean ± SD and represent the average of three replicates.
2.3. Statistical Analyses
For each analysis, triplicates of each condition were performed in three different replications. The data were subjected to a one- or two-way analysis of variance (ANOVA). Tukey tests were run on the data using GraphPad Prism 8.0.2 to determine whether treatment was statistically different from the others at a probability level of 0.05.
4. Conclusion
This study demonstrated the efficacy of bovine and human hemoglobin peptide hydrolysates in inhibiting the growth of a variety of bacteria, including S. aureus, L. monocytogenes, M. luteus, E. coli and S. Newport, K. rhizophila regardless of their initial substrate concentration from 1 to 10% (w/v). The results also highlighted the antioxidant capacities of these hydrolysates.Concerning human hemoglobin hydrolysates specifically, this study revealed for the first time to our knowledge the ability to inhibit the growth of certain bacteria as well as their ability to scavenge free radicals and prevent oxidative damage was highlighted.Therefore, some peptides in the hydrolysate fractions could be considered as powerful free radical scavengers and natural antimicrobial agents for potential use in food or cosmetic or pharmaceutical products.
Author Contributions
Conceptualization, NN, AO. and BE.; methodology, NN, AO, BE.; software, AO, BE, BD; validation, NN, AO, CF. and BD.; formal analysis, AO, NN.; investigation, AO, NN, JD, BE.; resources, NN, BG, BE.; data curation, AO, BE,NN.; writing—original draft preparation, AO, BE.; writing—review and editing, NN, AO, BE.; visualization, AO,NN, BE.; supervision, NN, BE.; project administration, NN.; BG. All authors have read and agreed to the published version of the manuscript.
Acknowledgments
The authors express their gratitude to the Advanced High Throughput Technologies Platform for Biorefineries Catalysts Design, known as "REALCAT," for their support. The REALCAT platform is funded by a French governmental subsidy administered by the French National Research Agency (ANR) as part of the "Future Investments" program (ANR-11-EQPX-0037). The authors would also like to acknowledge the financial contributions from the Hauts-de-France region, the FEDER (European Regional Development Fund), the Ecole Centrale de Lille, and the Centrale Initiatives Foundation, which enabled the acquisition of equipment for the REALCAT platform.
Conflicts of Interest
The authors declare no conflict of interest.
References
- Toldrá, F.; Aristoy, M.-C.; Mora, L.; Reig, M. Innovations in value-addition of edible meat by-products. Meat Sci. 2012, 92, 290–296. [Google Scholar] [CrossRef]
- Hsieh, Y.-H.P.; Ofori, J.A. Blood-derived products for human consumption, Revelation and Science. 1 (2011). 2011.
- Sasakawa, S. Studies on Hemoglobin VI. Amino Acid Compositions of the Fractionated Bovine Globin α and β. The Journal of Biochemistry 1961, 50, 345–351. [Google Scholar] [CrossRef] [PubMed]
- Schally, A.V.; Baba, Y.; Nair, R.; Bennett, C.D. The Amino Acid Sequence of a Peptide with Growth Hormone-releasing Activity Isolated from Porcine Hypothalamus. J. Biol. Chem. 1971, 246, 6647–6650. [Google Scholar] [CrossRef] [PubMed]
- Takagi, H.; Shiomi, H.; Ueda, H.; Amano, H. A novel analgesic dipeptide from bovine brain is a possible Met-enkephalin releaser. Nature 1979, 282, 410–412. [Google Scholar] [CrossRef]
- Fukui, K.; Shiomi, H.; Takagi, H.; Hayashi, K.; Kiso, Y.; Kitagawa, K. Isolation from bovine brain of a novel analgesic pentapeptide, neo-kyotorphin, containing The Tyr-Arg (kyotorphin) unit. Neuropharmacology 1983, 22, 191–196. [Google Scholar] [CrossRef]
- Zhao, Q.; Piot, J.M. Neokyotorphin Formation and Quantitative Evolution following Human Hemoglobin Hydrolysis with Cathepsin D. Peptides 1998, 19, 759–766. [Google Scholar] [CrossRef]
- Brantl, V.; Gramsch, C.; Lottspeich, F.; Mertz, R.; Jaeger, K.-H.; Herz, A. Novel opioid peptides defived from hemoglobin: Hemorphins. Eur. J. Pharmacol. 1986, 125, 309–310. [Google Scholar] [CrossRef] [PubMed]
- V. T. Ivanov, A.A. Karelin, M.M. Philippova, I.V. Nazimov, V.Z. Pletnev, Hemoglobin as a source of endogenous bioactive peptides: The concept of tissue-specific peptide pool. Peptide Science. 1997, 43, 171–188. [Google Scholar] [CrossRef]
- B. Lignot, R. Froidevaux, N. Nedjar-Arroume, D. Guillochon, Solvent effect on kinetics of appearance of neokyotorphin, VV-haemorphin-4 and a bradykinin-potentiating peptide in the course of peptic hydrolysis of bovine haemoglobin. Biotechnology and Applied Biochemistry. 1999, 30, 201–207. [Google Scholar]
- Zhao, Q.; Piot, J. Investigation of inhibition angiotensin-converting enzyme (ACE) activity and opioid activity of two hemorphins, LVV-hemorphin-5 and VV-hemorphin-5, isolated from a defined peptic hydrolysate of bovine hemoglobin. Neuropeptides 1997, 31, 147–153. [Google Scholar] [CrossRef] [PubMed]
- Vercaigne-Marko, D.; Kosciarz, E.; Nedjar-Arroume, N.; Guillochon, D. Improvement of Staphylococcus aureus-V8-protease hydrolysis of bovine haemoglobin by its adsorption on to a solid phase in the presence of SDS: peptide mapping and obtention of two haemopoietic peptides. Biotechnol. Appl. Biochem. 2000, 31, 127–134. [Google Scholar] [CrossRef]
- Adje, E.Y.; Balti, R.; Kouach, M.; Guillochon, D.; Nedjar-Arroume, N. α 67-106 of bovine hemoglobin: a new family of antimicrobial and angiotensin I-converting enzyme inhibitory peptides. Eur. Food Res. Technol. 2011, 232, 637–646. [Google Scholar] [CrossRef]
- Daoud, R.; Dubois, V.; Bors-Dodita, L.; Nedjar-Arroume, N.; Krier, F.; Chihib, N.-E.; Mary, P.; Kouach, M.; Briand, G.; Guillochon, D. New antibacterial peptide derived from bovine hemoglobin. Peptides 2005, 26, 713–719. [Google Scholar] [CrossRef]
- Nedjar-Arroume, N.; Dubois-Delval, V.; Adje, E.Y.; Traisnel, J.; Krier, F.; Mary, P.; Kouach, M.; Briand, G.; Guillochon, D. Bovine hemoglobin: An attractive source of antibacterial peptides. Peptides 2008, 29, 969–977. [Google Scholar] [CrossRef] [PubMed]
- Choisnard, L.; Froidevaux, R.; Nedjar-Arroume, N.; Lignot, B.; Vercaigne-Marko, D.; Krier, F.; Dhulster, P.; Guillochon, D. Kinetic study of the appearance of an anti-bacterial peptide in the course of bovine haemoglobin peptic hydrolysis. Biotechnol. Appl. Biochem. 2002, 36, 187–194. [Google Scholar] [CrossRef]
- Przybylski, R.; Firdaous, L.; Châtaigné, G.; Dhulster, P.; Nedjar, N. Production of an antimicrobial peptide derived from slaughterhouse by-product and its potential application on meat as preservative. Food Chem. 2016, 211, 306–313. [Google Scholar] [CrossRef] [PubMed]
- Parish, C.A.; Jiang, H.; Tokiwa, Y.; Berova, N.; Nakanishi, K.; McCabe, D.; Zuckerman, W.; Xia, M.M.; Gabay, J.E. Broad-spectrum antimicrobial activity of hemoglobin. Bioorganic Med. Chem. 2001, 9, 377–382. [Google Scholar] [CrossRef]
- Liepke, C.; Baxmann, S.; Heine, C.; Breithaupt, N.; Ständker, L.; Forssmann, W.-G. Human hemoglobin-derived peptides exhibit antimicrobial activity: a class of host defense peptides. J. Chromatogr. B 2003, 791, 345–356. [Google Scholar] [CrossRef]
- J. Gomes de Melo, T.A. de Sousa Araújo, V. Thijan Nobre de Almeida e Castro, D. Lyra de Vasconcelos Cabral, M. Do Desterro Rodrigues, S. Carneiro do Nascimento, E.L. Cavalcanti de Amorim, U.P. De Albuquerque, Antiproliferative activity, antioxidant capacity and tannin content in plants of semi-arid northeastern Brazil. Molecules. 2010, 15, 8534–8542. [Google Scholar]
- Catiau, L.; Traisnel, J.; Delval-Dubois, V.; Chihib, N.-E.; Guillochon, D.; Nedjar-Arroume, N. Minimal antimicrobial peptidic sequence from hemoglobin alpha-chain: KYR. Peptides 2010, 32, 633–638. [Google Scholar] [CrossRef]
- Nedjar-Arroume, N.; Dubois-Delval, V.; Miloudi, K.; Daoud, R.; Krier, F.; Kouach, M.; Briand, G.; Guillochon, D. Isolation and characterization of four antibacterial peptides from bovine hemoglobin. Peptides 2006, 27, 2082–2089. [Google Scholar] [CrossRef]
- Abou-Diab, M.; Thibodeau, J.; Deracinois, B.; Flahaut, C.; Fliss, I.; Dhulster, P.; Bazinet, L.; Nedjar, N. Bovine Hemoglobin Enzymatic Hydrolysis by a New Eco-Efficient Process-Part II: Production of Bioactive Peptides. Membranes 2020, 10, 268. [Google Scholar] [CrossRef]
- Borch, E.; Arinder, P. Bacteriological safety issues in red meat and ready-to-eat meat products, as well as control measures. Meat Sci. 2002, 62, 381–390. [Google Scholar] [CrossRef] [PubMed]
- Zhuang, H.; Tang, N.; Yuan, Y. Purification and identification of antioxidant peptides from corn gluten meal. J. Funct. Foods 2013, 5, 1810–1821. [Google Scholar] [CrossRef]
- Merouane, A.; Noui, A.; Medjahed, H.; Ali, K.N.B.; Saadi, A. Activité antioxydante des composés phénoliques d’huile d’olive extraite par méthode traditionnelle. Int. J. Biol. Chem. Sci. 2015, 8, 1865. [Google Scholar] [CrossRef]
- P. Molyneux, The use of the stable free radical diphenylpicrylhydrazyl (DPPH) for estimating antioxidant activity. Songklanakarin J. Sci. Technol. 2004, 26, 211–219. [Google Scholar]
- Re, R.; Pellegrini, N.; Proteggente, A.; Pannala, A.; Yang, M.; Rice-Evans, C. Antioxidant activity applying an improved ABTS radical cation decolorization assay. Free Radic. Biol. Med. 1999, 26, 1231–1237. [Google Scholar] [CrossRef]
- Qian, Z.-J.; Jung, W.-K.; Kim, S.-K. Free radical scavenging activity of a novel antioxidative peptide purified from hydrolysate of bullfrog skin, Rana catesbeiana Shaw. Bioresour. Technol. 2008, 99, 1690–1698. [Google Scholar] [CrossRef] [PubMed]
- Mak, P.; Wójcik, K.; Wicherek. ; Suder, P.; Dubin, A. Antibacterial hemoglobin peptides in human menstrual blood. Peptides 2004, 25, 1839–1847. [Google Scholar] [CrossRef]
- Dubois, V.; Nedjar-Arroume, N.; Guillochon, D. Influence of pH on the Appearance of Active Peptides in the Course of Peptic Hydrolysis of Bovine Haemoglobin. Prep. Biochem. Biotechnol. 2005, 35, 85–102. [Google Scholar] [CrossRef]
- E.Y. Adje, Hydrolyse ménagée de l’hémoglobine bovine par la pepsine porcine en mélanges hydroalcooliques et obtention d’une nouvelle famille de peptides antimicrobiens, Lille 1, 2010.
- V. Dubois, Préparation de peptides antimicrobiens à partir de l’hydrolyse enzymatique de deux protéines: l’hémoglobine bovine et l’α-lactalbumine bovine, Lille 1, 2006.
- Takagi, H.; Shiomi, H.; Fukui, K.; Hayashi, K.; Kiso, Y.; Kitagawa, K. Isolation of a novel analgesic pentapeptide, neo-kyotorphin, from bovine brain. Life Sci. 1982, 31, 1733–1736. [Google Scholar] [CrossRef] [PubMed]
- Zhao, Q.; Sannier, F.; Piot, J.M. Kinetics of appearance of four hemorphins from bovine hemoglobin peptic hydrolysates by HPLC coupled with photodiode array detection. Biochim. et Biophys. Acta (BBA) - Protein Struct. Mol. Enzym. 1996, 1295, 73–80. [Google Scholar] [CrossRef]
- Froidevaux, R.; Krier, F.; Nedjar-Arroume, N.; Vercaigne-Marko, D.; Kosciarz, E.; Ruckebusch, C.; Dhulster, P.; Guillochon, D. Antibacterial activity of a pepsin-derived bovine hemoglobin fragment. FEBS Lett. 2001, 491, 159–163. [Google Scholar] [CrossRef]
- Marco, G.J. A rapid method for evaluation of antioxidants. J. Am. Oil Chem. Soc. 1968, 45, 594–598. [Google Scholar] [CrossRef]
- Koleva, I.I.; van Beek, T.A.; Linssen, J.P.H.; de Groot, A.; Evstatieva, L.N. Screening of Plant Extracts for Antioxidant Activity: a Comparative Study on Three Testing Methods. Phytochem. Anal. 2002, 13, 8–17. [Google Scholar] [CrossRef] [PubMed]
- Bersuder, P.; Hole, M.; Smith, G. Antioxidants from a heated histidine-glucose model system. I: Investigation of the antioxidant role of histidine and isolation of antioxidants by high-performance liquid chromatography. J. Am. Oil Chem. Soc. 1998, 75, 181–187. [Google Scholar] [CrossRef]
- Gülçin, Antioxidant properties of resveratrol: A structure–activity insight. Innovative Food Science & Emerging Technologies 2010, 11, 210–218.
- Maisuthisakul, P.; Pongsawatmanit, R.; Gordon, M.H. Characterization of the phytochemicals and antioxidant properties of extracts from Teaw (Cratoxylum formosum Dyer). Food Chem. 2007, 100, 1620–1629. [Google Scholar] [CrossRef]
- Prieto, P.; Pineda, M.; Aguilar, M. Spectrophotometric Quantitation of Antioxidant Capacity through the Formation of a Phosphomolybdenum Complex: Specific Application to the Determination of Vitamin E. Anal. Biochem. 1999, 269, 337–341. [Google Scholar] [CrossRef] [PubMed]
Figure 2.
β-carotene bleaching inhibition activity of hemoglobin human and bovine hydrolysates at different concentrations. A and B show that the variation in relative antioxidant activity (RAA) is dependent on concentration (mg/mL) and not on the initial hemoglobin substrate concentration (1,2,8 and 10% (w/v)). In B and D, values marked with a symbol (*) are significantly different from BHT; values marked with a symbol (*) are significantly different from neokyotorphin (NKT) at the same concentration and under the same conditions; *p < 0.05, multiple comparison t tests using the Bonferroni-Dum method).
Figure 2.
β-carotene bleaching inhibition activity of hemoglobin human and bovine hydrolysates at different concentrations. A and B show that the variation in relative antioxidant activity (RAA) is dependent on concentration (mg/mL) and not on the initial hemoglobin substrate concentration (1,2,8 and 10% (w/v)). In B and D, values marked with a symbol (*) are significantly different from BHT; values marked with a symbol (*) are significantly different from neokyotorphin (NKT) at the same concentration and under the same conditions; *p < 0.05, multiple comparison t tests using the Bonferroni-Dum method).
Figure 3.
DPPH scavenging activity of hemoglobin hydrolysates of human (A) and bovine (B) at different concentrations (1, 5, 10 mg/mL) with different percentage of purification of hemoglobin hydrolysates (1-10 %). Comparisons were realized between different concentration of each percentage within the same condition. C) Comparison between activity of DPPH of hemoglobin hydrolysates of human and bovine at different concentrations (1, 10 mg/mL) à 1 % of purification of hemoglobin hydrolysates. ***p<0.001 (One-way ANOVA and Tukey’ multiple comparisons test). ns p>0.05 (paired t-test).
Figure 3.
DPPH scavenging activity of hemoglobin hydrolysates of human (A) and bovine (B) at different concentrations (1, 5, 10 mg/mL) with different percentage of purification of hemoglobin hydrolysates (1-10 %). Comparisons were realized between different concentration of each percentage within the same condition. C) Comparison between activity of DPPH of hemoglobin hydrolysates of human and bovine at different concentrations (1, 10 mg/mL) à 1 % of purification of hemoglobin hydrolysates. ***p<0.001 (One-way ANOVA and Tukey’ multiple comparisons test). ns p>0.05 (paired t-test).
Figure 4.
Percentage of ABTS radical inhibition of human (A) and bovine (B) hemoglobin hydrolysates at different concentrations (1, 5, 10 mg/mL) with different percentages of initial bovine/human hemoglobin substrate of the hydrolysates (1-10%). Comparisons were made between the different concentrations of each percentage under the same conditions. C) Comparison between ABTS radical inhibition of human and bovine hemoglobin hydrolysates at different concentrations (1, 10 mg/mL) at 1% purification of hemoglobin hydrolysates. ***p<0.001 (one-way ANOVA and Tukey's multiple comparisons test). ns p>0.05 (paired t test).
Figure 4.
Percentage of ABTS radical inhibition of human (A) and bovine (B) hemoglobin hydrolysates at different concentrations (1, 5, 10 mg/mL) with different percentages of initial bovine/human hemoglobin substrate of the hydrolysates (1-10%). Comparisons were made between the different concentrations of each percentage under the same conditions. C) Comparison between ABTS radical inhibition of human and bovine hemoglobin hydrolysates at different concentrations (1, 10 mg/mL) at 1% purification of hemoglobin hydrolysates. ***p<0.001 (one-way ANOVA and Tukey's multiple comparisons test). ns p>0.05 (paired t test).
Figure 5.
Total antioxidant capacity of human (A) and bovine (B) hemoglobin hydrolysates at different concentrations. Comparison between human and bovine (C). Values with symbol (*) are significantly different from BHT; values with symbol (*) are significantly different from NKT*p < 0.05, one-way ANOVA followed by Dunnett's multiple comparison test. Values with a letter (a) in the same concentration are significantly different (p < 0.05, Tukey).
Figure 5.
Total antioxidant capacity of human (A) and bovine (B) hemoglobin hydrolysates at different concentrations. Comparison between human and bovine (C). Values with symbol (*) are significantly different from BHT; values with symbol (*) are significantly different from NKT*p < 0.05, one-way ANOVA followed by Dunnett's multiple comparison test. Values with a letter (a) in the same concentration are significantly different (p < 0.05, Tukey).
Figure 6.
Study of the antimicrobial and antioxidant activity and peptidomic analysis of human and bovine hemoglobin hydrolysate fractions after a 3-hour hydrolysis period (pH 3,5, 23°C, E/S = 1/11, CBH = 10%, CHH= 10%, w/v). Fractions were collected every 5 minutes. (A) Chromatographic hydrolysis profiles of bovine and human hemoglobin acquired using Waters software at 215 nm by semi-preparative HPLC, analysed by a semi-preparative C4 column. (B) Percentage ABTS inhibition of human and bovine hemoglobin hydrolysate fractions at a concentration of 20 mg/mL. (C) Peptidomic analysis using UPLC-MS/MS and bioinformatics. Histogram showing the number of unique peptide sequences identified.
Figure 6.
Study of the antimicrobial and antioxidant activity and peptidomic analysis of human and bovine hemoglobin hydrolysate fractions after a 3-hour hydrolysis period (pH 3,5, 23°C, E/S = 1/11, CBH = 10%, CHH= 10%, w/v). Fractions were collected every 5 minutes. (A) Chromatographic hydrolysis profiles of bovine and human hemoglobin acquired using Waters software at 215 nm by semi-preparative HPLC, analysed by a semi-preparative C4 column. (B) Percentage ABTS inhibition of human and bovine hemoglobin hydrolysate fractions at a concentration of 20 mg/mL. (C) Peptidomic analysis using UPLC-MS/MS and bioinformatics. Histogram showing the number of unique peptide sequences identified.
Table 2.
Antibacterial peptide hydrolysates.
Table 2.
Antibacterial peptide hydrolysates.
| |
Bovine Hemoglobin Hydrolysates |
| Bacteria strains |
1% |
2% |
8% |
10% |
| Kocuriarhizophila |
0.15 ± 0.0 aa
|
0.15 ± 0.0 aa
|
0.15 ± 0.0 aa
|
0.15± 0.0 aa
|
| Staphylococcus aureus |
0.31 ± 0.0 aa
|
0.31 ± 0.0 aa
|
0.31 ± 0.0 aa
|
0.31 ± 0.0 aa
|
| Listeria monocytogenes |
0,62 ±0.0aa
|
0,62 ±0.0 aa
|
0,62±0.0 aa
|
0,62 ± 0.0 aa
|
| Escherichia coli |
10 ± 0.0 aa
|
10 ± 0.0 aa
|
10 ± 0.0 aa
|
10 ± 0.0 aa
|
| Salmonelle Newport |
5± 0.0 ab
|
5± 0.0 ab
|
5 ± 0.0 ab
|
5 ± 0.0 ab
|
| Micrococcus luteus |
5 ± 0.0 aa
|
5 ± 0.0 aa
|
5 ± 0.0 aa
|
5 ± 0.0 aa
|
| |
Human Hemoglobin Hydrolysates |
| Bacteria strains |
1% |
2% |
8% |
10% |
| Kocuriarhizophila |
0.15 ± 0.0 aa
|
0.15 ± 0.0 aa
|
0.15 ± 0.0 aa
|
0.15± 0.0 aa
|
| Staphylococcus aureus |
0.31 ± 0.0 aa
|
0.31 ± 0.0 aa
|
0.31 ± 0.0 aa
|
0.31 ± 0.0 aa
|
| Listeria monocytogenes |
0,62 ±0.0 aa
|
0,62 ±0.0 aa
|
0,62±0.0 aa
|
0,62 ± 0.0 aa
|
| Escherichia coli |
10 ± 0.0 aa
|
10 ± 0.0 aa
|
10 ± 0.0 aa
|
10 ± 0.0 aa
|
| Salmonelle Newport |
10 ± 0.0 ab
|
10± 0.0 ab
|
10 ± 0.0 ab
|
10 ± 0.0 ab
|
| Micrococcus luteus |
5 ± 0.0 aa
|
5 ± 0.0 aa
|
5 ± 0.0 aa
|
5 ± 0.0 aa
|
Table 3.
: Trolox Equivalent Antioxidant Capacity (TEAC)
Table 3.
: Trolox Equivalent Antioxidant Capacity (TEAC)
| Purification |
1% |
2% |
8% |
10% |
NKT |
TROLOX |
| EC50 (mg/mL) |
Human |
3.07 ± 0.34ns
|
2.63 ± 0.31 *
|
2.45 ± 0.28 *
|
2.68 ± 0.32 ns
|
0.83 ±0.09 |
0.38±0.03 |
| Bovine |
3.83 ± 0.40ns
|
3.26 ± 0.36 *
|
3.01 ± 0.32 *
|
3.22 ± 0.38 ns
|
|
|
| TEAC |
Human |
0.12±0.05ns
|
0.14±0.04 ns
|
0.15±.,05 ns
|
0.14±0.04 ns
|
0.45±0.07 |
1 |
| Bovine |
0.10±0.02 |
0.12±0,04 |
0.13±0.04 |
0.12±0.03 |
|
|
Table 4.
Hemoglobin bovine and human hydrolysates for ABTS method.
Table 4.
Hemoglobin bovine and human hydrolysates for ABTS method.
| Purification |
1 % |
2 % |
8 % |
10 % |
NKT |
TROLOX |
| EC50 (mg/mL) |
Human |
3.24±0.38 |
3.56±0.45ns
|
3.30±0.65ns
|
3.26±0.38ns
|
0.64±0.06 |
0.58±0.07 |
| Bovine |
4.10±0.56 |
3.74±0.53 |
4.38±0.56 |
3.88±0.49 |
- |
- |
| TEAC |
Human |
0.16±0.05ns
|
0.16±0.06ns
|
0.17±0.04ns
|
0.17±0.03ns
|
0.90±0.05 |
1 |
| Bovine |
0.14±0.04 |
0.15±0.06 |
0.13±0.05 |
0.15±0.04 |
- |
- |
|
Disclaimer/Publisher’s Note: The statements, opinions and data contained in all publications are solely those of the individual author(s) and contributor(s) and not of MDPI and/or the editor(s). MDPI and/or the editor(s) disclaim responsibility for any injury to people or property resulting from any ideas, methods, instructions or products referred to in the content. |
© 2023 by the authors. Licensee MDPI, Basel, Switzerland. This article is an open access article distributed under the terms and conditions of the Creative Commons Attribution (CC BY) license (http://creativecommons.org/licenses/by/4.0/).